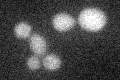
YIR028W
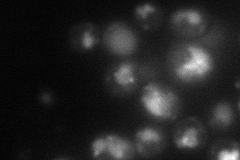
YIR028W
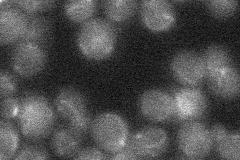
YIR028W

View description
Allantoin permease; expression sensitive to nitrogen catabolite repression and induced by allophanate, an intermediate in allantoin degradation
Localization:
Intensity:
Fold change:
Significance:
-
C’ GFP library in SD
below threshold15.54 -
N' NOP1pr-GFP in SD
vacuole68.9232 -
N' TEF2pr-mCherry in SD

vacuole86.6411 -
N' NATIVEpr-GFP in SD
below threshold15.5278 -
N' TEF2pr-VC and Cyto-VN in SD

below threshold26.4476 -
C’ GFP library in SD+DTT

cytosol15.20.97No -
C’ GFP library in SD+H2O2

cytosol16.971.09No -
C’ GFP library in Starvation Media

vacuole69.334.46No -
C’ GFP library on the background of Pup2-DaMP

below threshold -
C’ GFP library on the background of CCT mutant

below threshold15.14710.974326No
